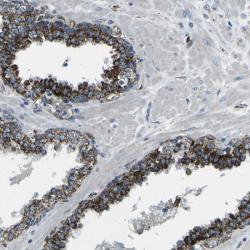

Antibody data
- Antibody Data
- Antigen structure
- References [2]
- Comments [0]
- Validations
- Western blot [1]
- Immunohistochemistry [1]
Submit
Validation data
Reference
Comment
Report error
- Product number
- sc-21732 - Provider product page

- Provider
- Santa Cruz Biotechnology
- Proper citation
- Santa Cruz Biotechnology Cat#sc-21732, RRID:AB_627958
- Product name
- Anti-MMP3
- Antibody type
- Monoclonal
- Reactivity
- Human
- Host
- Mouse
Submitted references Matrix metalloproteinase 3 is present in the cell nucleus and is involved in apoptosis.
A reinforced merging methodology for mapping unique peptide motifs in members of protein families.
Si-Tayeb K, Monvoisin A, Mazzocco C, Lepreux S, Decossas M, Cubel G, Taras D, Blanc JF, Robinson DR, Rosenbaum J
The American journal of pathology 2006 Oct;169(4):1390-401
The American journal of pathology 2006 Oct;169(4):1390-401
A reinforced merging methodology for mapping unique peptide motifs in members of protein families.
Chang HT, Pai TW, Fan TC, Su BH, Wu PC, Tang CY, Chang CT, Liu SH, Chang MD
BMC bioinformatics 2006 Jan 25;7:38
BMC bioinformatics 2006 Jan 25;7:38
No comments: Submit comment
Supportive validation
- Submitted by
- per
- Main image

- Experimental details
- Western blot analysis of antibody specificity using a routine panel composed of IgG/HSA-depleted human plasma and protein lysates from selected human tissues and cell lines.
- Validation comment
- Band of predicted size in kDa (+/-20%) with additional bands present.
- Primary Ab dilution
- 1:500
- Secondary Ab dilution
- 1:7000
- Lane 1
- Marker [kDa]: 250, 130, 95, 72, 55, 36, 28, 17, 11
- Lane 2
- RT-4
- Lane 3
- U-251MG sp
- Lane 4
- Human Plasma
- Lane 5
- Liver
- Lane 6
- Tonsil
- Theoretical target weight
- [kDa] 54
Supportive validation
- Submitted by
- per
- Main image
- Experimental details
- Immunohistochemical staining of human prostate shows distinct cytoplasmic positivity in glandular cells.
- Validation comment
- Staining pattern consistent with experimental and/or bioinformatic data.